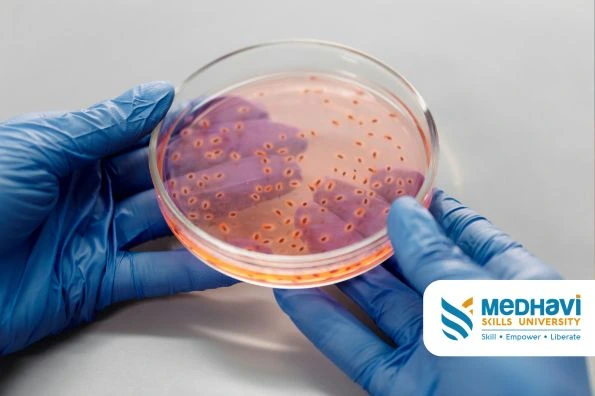

According to the Indian Brand Equity Foundation, the Indian biotechnology industry has the potential to reach 270-300 billion USD by the year 2030. Biotechnology is one of the most rapidly evolving sectors in India right now. With revolutionary revelations taking place and with scope of even more growth in the sector, it can be a great option for candidates willing to launch their careers in a dynamic field. This blog discusses in detail about the three major career pathways that you can explore if you pursue a B.Sc. in Biotechnology program which includes research, pharma, and bioinformatics.

What is Biotechnology?
Biotechnology is a branch in the field of science that combines both biology and technology with the intention of making discoveries to improve the quality of people’s life and the environment. It uses living cells, organisms, or biomolecules to discover or develop solutions and products in sectors like agriculture, medicine, and industrial applications. The sector is involved with a lot of things, from making life-saving drugs, to industrial products, to sustainable agricultural components. Biotechnology plays a crucial role in the advancement of modern science and technology.
Education required to become a Biotechnology professional
One of the most accessible and easiest ways to enter the field of biotechnology is by pursuing a B.Sc. in Biotechnology program. It is usually a three year long undergraduate program that teaches the students both the theoretical and practical skills required to thrive in the field of biotechnology. It provides knowledge on various crucial aspects of the field like genetics, molecular biology, biochemistry, microbiology, etc. Any candidate having completed their 10+2 with science can pursue this program.
Now, many colleges and universities in India provide a B.Sc in Biotechnology program but then again, it does give the student a certain edge if they complete it from a credible university. Medhavi Skills University is one of the best B.Sc. in Biotechnology colleges in India right now. Since it is a skills-based university, MSU offers the student a comprehensive learning experience combining both theoretical knowledge and practical expertise with hands-on learning, on-the-job experience, and practical exposure.

Career pathways in Biotechnology
Research and Development (R&D) - Research, innovation, and development is a key aspect in the field of biotechnology. B.Sc. in Biotechnology program graduates can choose to work in R&D and contribute to groundbreaking innovations and discoveries in the field of healthcare, genetics, agriculture, and more. Roles include -
- Genetic Engineering - Work with gene editing technologies like CRISPR to find innovations and modify genetic structures.
- Microbiologist - Develop and create probiotics and antibiotics by studying microorganisms.
- Biomedical Scientist - Contribute to developing new medical treatments and vaccines by conducting research.
- Biochemist - Work in developing drugs and diagnostic tools by researching biological processes.
Pharmaceutical and Biopharmaceutical Industry - The pharmaceutical and biopharmaceutical industry is considered to be one of the largest employers of B.Sc. in Biotechnology program graduates. They work in the field of drug discovery, development, quality control and production. They play a very crucial role in the healthcare sector. Roles include -
- Clinical Research Associate - Work in managing clinical trials for new found medical treatments and drugs.
- Regulatory Affairs Specialist - Making sure that the pharmaceutical products produced match the set government regulations.
- Bioprocess Engineer - Developing strategies to optimize processes in large-scale drug production.
- Quality Control Analyst - Work in monitoring the safety and quality of biotech products.
- Bioinformatics - Bioinformatics is a newer field that has emerged as a crucial part in the field of biotechnology. It combines biology with computer science to make analyzing genetic and molecular data easier. B.Sc. in Biotechnology program graduates can also choose to explore this dynamic field. Roles include -
- Bioinformatics Scientist - Interpret biological data by developing softwares, tools, and algorithms.
- Genomics Analyst - Work in the formulation of personalized medicine and genome sequencing.
- Computational Biologist - Study genetics structures and protein functions by using data modeling.
- AI and Machine Learning Specialist in Biotechnology - Work in predicting drug interactions and developing precision medicine by utilizing AI.
Biotechnology is a field of science that is rapidly evolving and expanding. Students who have a passion for innovation and want to contribute to the advancement of science and technology are the perfect fit for a career in the domain. B.Sc. in Biotechnology program graduates can explore a lot of career opportunities in the field, the three most popular and in-demand domains have been discussed in the section above.
Why choose Medhavi Skills University for a career in Biotechnology?
Medhavi Skills University (MSU) is one of the leading institutions offering skill-based education in biotechnology. Here’s why MSU is the perfect choice for aspiring biotechnologists:
- NEP 2020 Aligned & UGC Recognized – The program is designed to meet modern educational standards, ensuring industry relevance.
- Hands-on Learning – Students gain practical exposure through lab work, internships, and industry projects.
- Industry Collaboration – Partnerships with top biotech firms provide students with real-world experience.
- Expert Faculty & Mentorship – Guidance from experienced researchers and industry professionals ensures quality education.
- Skill-Based Curriculum – A major portion of the curriculum is dedicated to practical learning, including case studies, research projects, and real-time assessments. 70% of the curriculum is practical oriented.
- Career Support & Placement Assistance – MSU offers career counseling, placement support, and networking opportunities to help students secure job placements in reputed institutions.
- State-of-the-Art Labs – The university is equipped with advanced biotech and bioinformatics labs to facilitate hands-on training.












